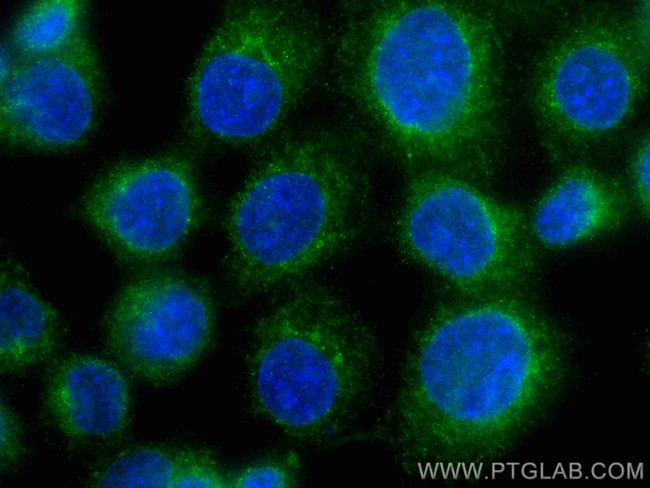
RASEF Antibody in Immunocytochemistry (ICC/IF)

Search
Proteintech
RASEF Monoclonal Antibody (1C2B2), CoraLite® Plus 488
{{$productOrderCtrl.translations['antibody.pdp.commerceCard.promotion.promotions']}}
{{$productOrderCtrl.translations['antibody.pdp.commerceCard.promotion.viewpromo']}}
{{$productOrderCtrl.translations['antibody.pdp.commerceCard.promotion.promocode']}}: {{promo.promoCode}} {{promo.promoTitle}} {{promo.promoDescription}}. {{$productOrderCtrl.translations['antibody.pdp.commerceCard.promotion.learnmore']}}
产品信息
CL488-67159
种属反应
宿主/亚型
分类
类型
克隆号
抗原
偶联物
激发/发射光谱
形式
纯化类型
保存液
内含物
保存条件
运输条件
产品详细信息
Immunogen sequence: DGLRSALENS YSKFNRSLHI NNISPGNTIS RSSPKFIGHS PQPLGYDRSS RSSYVDEDCD SLALCDPLQR TNCEVDSLPE SCFDSGLSTL RDPNEYDSEV EYKHQRGFQR SHGVQESFGG DASDTDVPDI RDEETFGLED VASVLDWKPQ GSVSEGSIVS SSRKPISALS PQTDLVDDNA KSFSSQKAYK IVLAGDAAVG KSSFLMRLCK NEFRENISAT LGVDFQMKTL IVDGERTVLQ LWDTAGQERF RSIAKSYFRK ADGVLLLYDV TCEKSFLNIR EWVDMIEDAA HETVPIMLVG NKADIRDTAA TEGQKCVPGH FGEKLAMTYG ALFCETSAKD GSNIVEAVLH LAREVKKRTD KDDSRSITNL TGTNSKKSPQ MKNCCNG
靶标信息
Binds predominantly GDP, and also GTP.
仅用于科研。不用于诊断过程。未经明确授权不得转售。
篇参考文献 (0)
生物信息学
蛋白别名: Ras and EF-hand domain-containing protein; Ras-related protein Rab-45; unnamed protein product
基因别名: RAB45; RASEF; TSG
UniProt ID: (Human) Q8IZ41
Entrez Gene ID: (Human) 158158